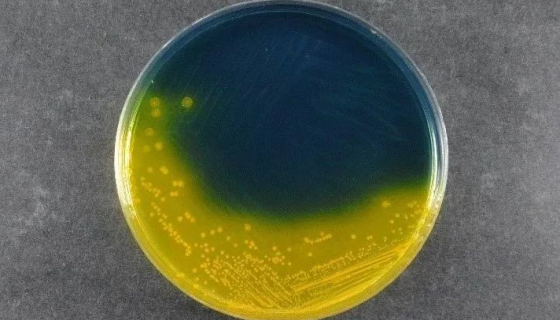
TCBS琼脂弧菌检测的方法和手段准确吗？
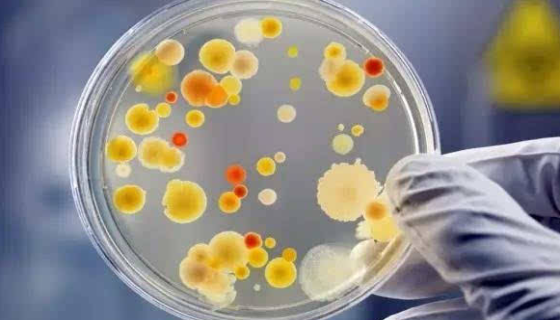
检验技术：消毒与灭菌效果的评价方法与标准！
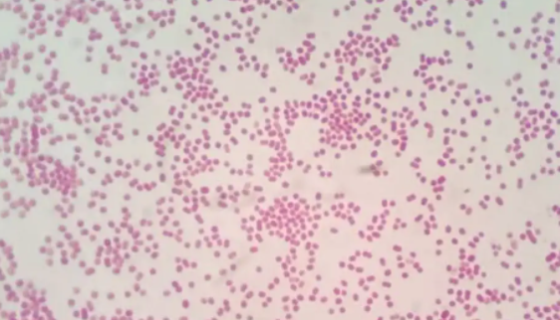
鲍曼不动杆菌的流行病学与临床表现及菌种鉴定！
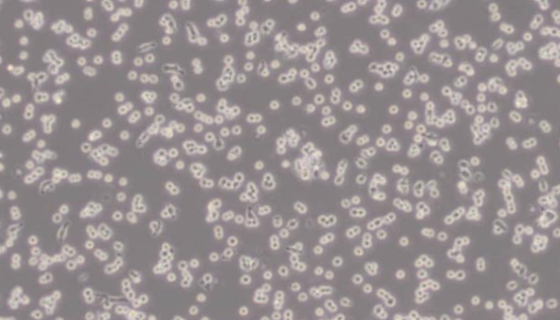
C1498小鼠白血病细胞的处理方法与培养步骤！

大鼠胰腺外分泌细胞的处理方法与培养步骤!
AR42J细胞在肾上腺皮质激素刺激下可诱导出外分泌活性,并伴...
TCBS琼脂弧菌检测的方法和手段准确吗?
TCBS琼脂培养基主要用于副溶血弧菌和霍乱的分离培养。在南美...

绿色魏斯氏菌——用于生产青贮饲料和制作泡菜
绿色魏斯氏菌是Weissella属的微生物,原产地为中国。主...

人脑血管平滑肌细胞的培养操作说明及注意事项!
人血管平滑肌细胞的体外培养是血管研究中的重要模型,并将对血管...
检验技术:消毒与灭菌效果的评价方法与标准!
消毒与灭菌效果的评价方法与标准。

少孢酵母的培养方法及冻干管打管说明!
少孢酵母是Saccharomyces属的微生物,原产地为中国...

狗脐静脉内皮细胞的运输和保存及使用方法!
狗脐静脉内皮细胞的实验室分离方法与质量检测及使用方法。
鲍曼不动杆菌的流行病学与临床表现及菌种鉴定!
鲍曼不动杆菌为非发酵革兰阴性杆菌,广泛存在于自然界,属于条件...
C1498小鼠白血病细胞的处理方法与培养步骤!
小鼠白血病细胞收到后的处理方法与培养步骤及注意事项有哪些?